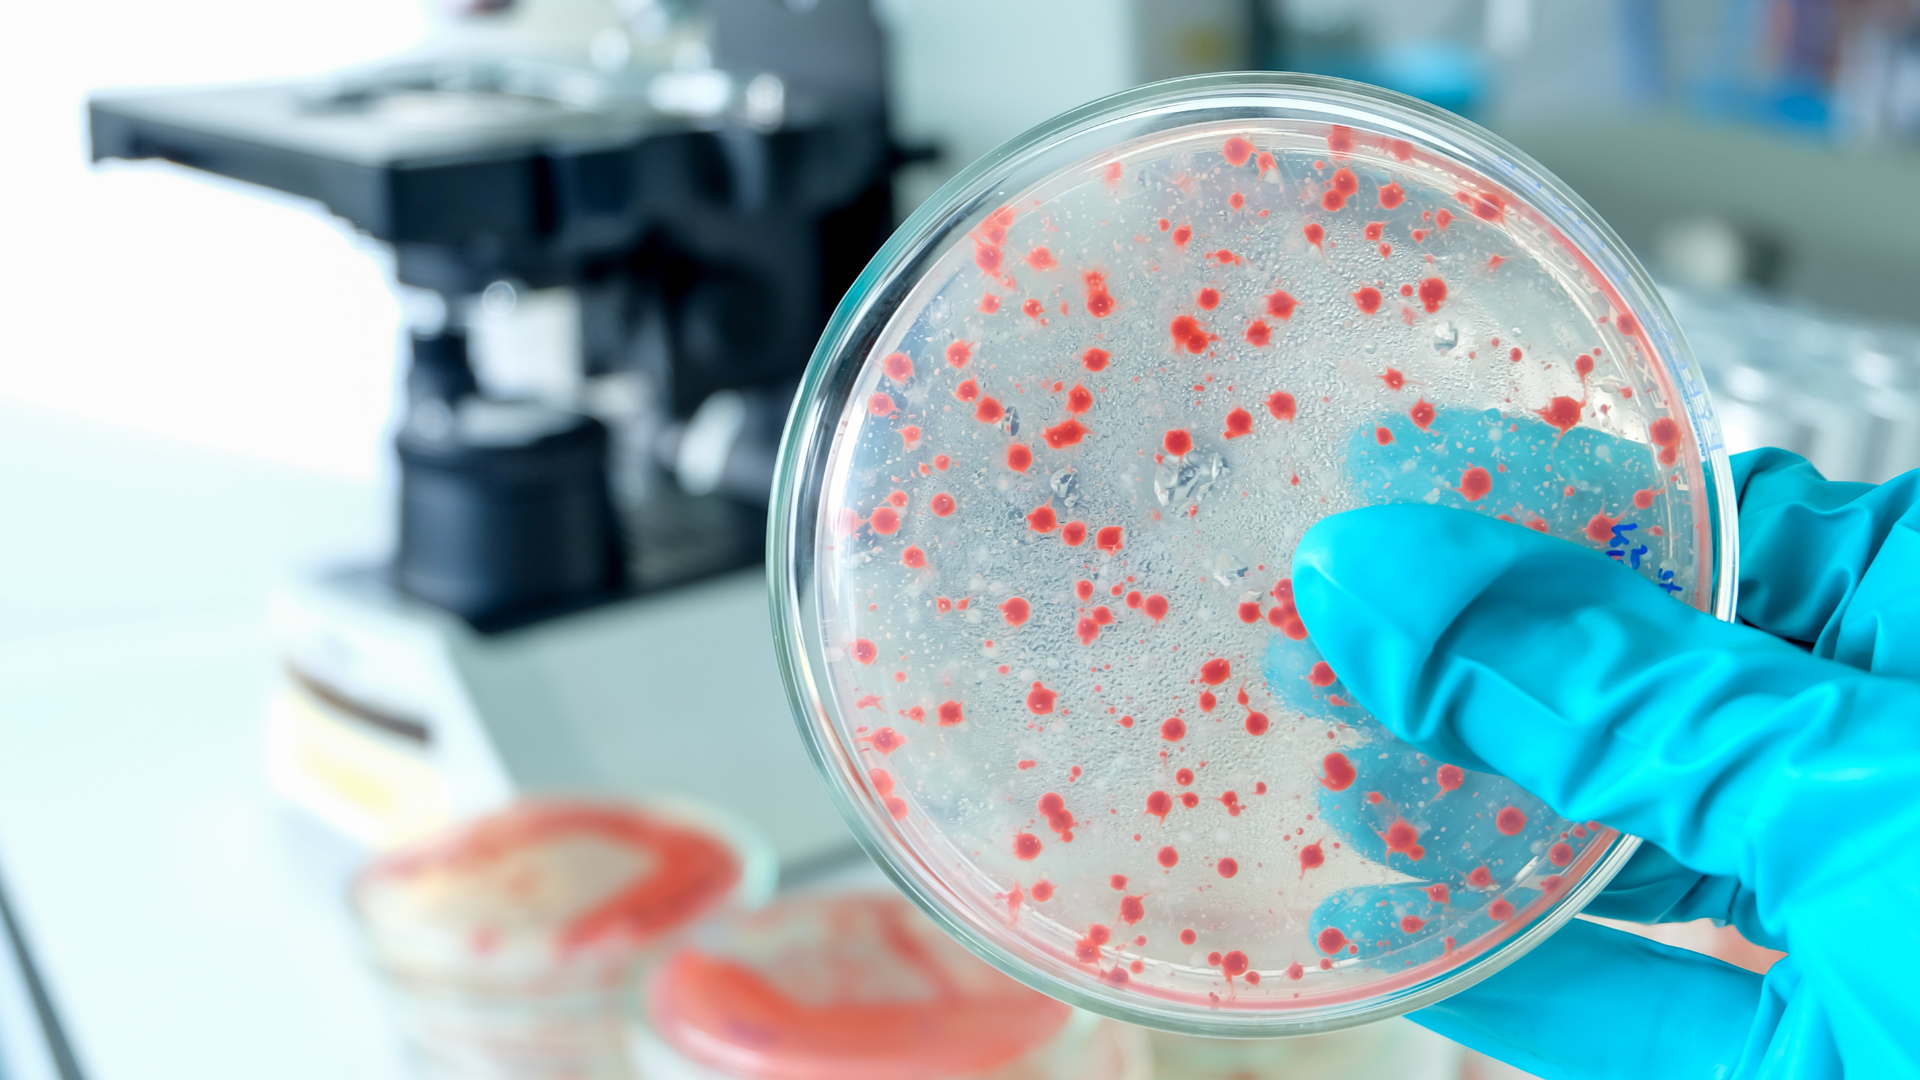

Garantissez la conformité et la sécurité de vos produits grâce à nos solutions complètes en réglementation et toxicologie.
Où que vous soyez, bénéficiez de l’expertise d’un réseau international de laboratoires accrédités ! Eurofins C&PC vous accompagne avec des solutions sur mesure, des délais optimisés et une parfaite maîtrise des exigences réglementaires.


Garantissez la conformité et la sécurité de vos produits grâce à nos solutions complètes en réglementation et toxicologie.

L’analyse, c’est notre ADN : nous garantissons la sécurité, la qualité et la conformité de vos matières premières, produits et emballages. Avec des technologies de pointe et des solutions innovantes, nous vous aidons à respecter les standards mondiaux et à renforcer la confiance de vos clients.
La qualité microbiologique est essentielle à la sécurité des produits cosmétiques. Toute contamination peut compromettre leur sécurité, leur stabilité et l’image de la marque. Nos tests microbiologiques précis et conformes à la réglementation garantissent l’intégrité de vos produits et sécurisent vos lancements sur le marché.

Assurez la sécurité environnementale de vos produits cosmétiques grâce à nos tests d’écotoxicité et de biodégradabilité. Entièrement conformes aux normes internationales, nos analyses soutiennent les certifications éco-labels et vous aident à répondre aux exigences mondiales en matière de durabilité.

Découvrez des solutions de soins personnalisés grâce à l’analyse génomique avancée, pour améliorer la santé et la beauté de votre peau.

Explorez nos services complets de tests in vitro pour garantir la sécurité et l’efficacité de vos produits cosmétiques. Profitez de plus de 30 ans d’expertise et de technologies de pointe.

Évaluez l’efficacité de vos produits cosmétiques dans des conditions réalistes grâce à nos tests précis et fiables réalisés sur des explants de peau humaine ex vivo.

Réalisez des essais cliniques in vivo robustes pour garantir la sécurité, l’efficacité et la satisfaction des consommateurs. Nos solutions, testées par des scientifiques et des cliniciens, sont adaptées à des populations variées et à des allégations spécifiques.

Validez vos allégations d’efficacité grâce à des technologies d’imagerie numérique de pointe et à nos logiciels internes. Capturez des résultats avant/après détaillés pour illustrer les effets anti-âge, l’uniformisation du teint et d’autres bénéfices cosmétiques.

Comprenez ce que les consommateurs ressentent et préfèrent : nos tests sensoriels et consommateurs, accessibles et efficaces, vous aident à affiner vos formules, valider vos promesses et maximiser l’impact de vos produits sur le marché.
Mesurez l’impact émotionnel de vos produits grâce à des techniques de pointe. Nos études émotionnelles analysent les réponses physiologiques, cognitives et comportementales des consommateurs pour renforcer le lien entre votre marque et son public.

Assurez la conformité internationale et optimisez votre efficacité opérationnelle grâce aux solutions personnalisées d’audit, de conseil et de formation d’Eurofins Cosmetics and Personal Care. Bénéficiez d’un accès rapide aux marchés et améliorez la qualité de vos produits avec l’appui de nos experts.

Eurofins PSS Insourcing Solutions® met à votre disposition une expertise scientifique personnalisée directement sur site. Améliorez votre efficacité opérationnelle, assurez votre conformité et obtenez des résultats exceptionnels grâce à nos équipes dédiées.

Restez informé des dernières actualités d'Eurofins Cosmetics and Personal Care.

Découvrez nos bulletins mensuels et les informations exclusives fournies par notre réseau international de laboratoires d'essais dans le domaine des cosmétiques et des soins personnels. Restez à la pointe de l'actualité grâce aux dernières innovations en matière d'essais, aux évolutions réglementaires et aux tendances du secteur.

Découvrez les prochains événements d'Eurofins Cosmetics & Personal Care : salons professionnels, webinaires, podcasts d'experts, séminaires et conférences. Rejoignez-nous pour découvrir les solutions de test, les informations sur le secteur et les mises à jour réglementaires de notre réseau mondial de laboratoires.



